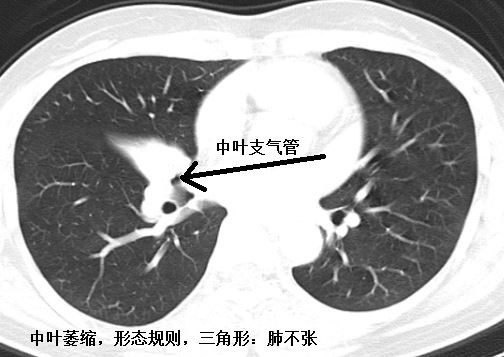
肺不张ct读片太难看完这篇文章轻松入门

肺不张ct图片图解

肺不张影像表现
图片尺寸751x901
肺不张影像表现
图片尺寸748x912
肺不张影像表现
图片尺寸834x829
轻松搞定肺不张,肺ct入门难点之一
图片尺寸527x407
不同部位肺不张的影像特点
图片尺寸920x690
供临床医学大专医学影像诊断用 2,肺不张 ——支气管完全阻塞时,气体
图片尺寸1080x810
胸部ct肺段划分口诀word编辑
图片尺寸920x1302
ct肺段定位口诀
图片尺寸600x460肺不张ct读片太难?看完这篇文章轻松入门!
图片尺寸554x399
ct肺的分叶分段
图片尺寸920x1302
肺不张ct读片太难看完这篇文章轻松入门
图片尺寸504x357
ct肺分叶分段ct实图及模拟分段图
图片尺寸920x1302肺不张ct读片太难?看完这篇文章轻松入门!
图片尺寸553x399肺不张ct读片太难?看完这篇文章轻松入门
图片尺寸548x439
肺不张ct读片太难看完这篇文章轻松入门
图片尺寸432x357
ct肺窗横断层解剖.22ppt课件
图片尺寸860x7635肺不张ct读片太难?看完这篇文章轻松入门!
图片尺寸553x412
不毒拖略匕,查找使用更方便7积分下载资源资源描述:《正常胸部肺窗ct
图片尺寸920x1302肺不张ct读片太难?看完这篇文章轻松入门!
图片尺寸402x307肺不张ct读片太难?看完这篇文章轻松入门!
图片尺寸541x388
猜你喜欢:正常肺ct片图片图解肺不张ct图片肺不张胸片表现图片肺不张ct经典图片肺不张ct表现图片肺不张x线图片肺不张图片肺部ct图片正常图肺不张影像图片肺不张x线表现图片肺不张ct肺气肿的ct图片肺部ct图片肺不张胸片肺不张ct表现肺实变ct图片肺脓肿ct图片肺不张胸片表现肺癌ct图片肺部ct怎么看图解解读肺部ct怎么看图解肺气肿的ct表现图片肺不张x线怎么看肺部ct片子图解正常人的肺部ct图片肺不张x线表现健康人肺的ct高清图片肺不张脑梗图片ct肺不张影像学裱花嘴型号陕西芙蓉玉2020款poloplus阿丽拉乌镇酒店巨爵座圣衣分解图千云兮 单人辽宁盘锦杨幂丈夫刘恺威宁波主持人事件公寓外立面设计亚特兰蒂斯真的存在吗张靓颖三环照片